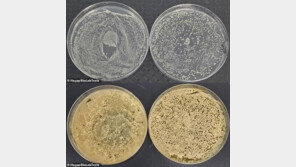
전자담배 흡입구 ‘세균 득실’…공중화장실 변기보다 3000배 더럽다

![겨울철 기력 살릴 ‘바다의 우유’, 굴[정세연의 음식처방]](https://dimg.donga.com/a/296/167/95/2/wps/NEWS/IMAGE/2025/11/23/132823094.4.jpg)
겨울철 기력 살릴 ‘바다의 우유’, 굴[정세연의 음식처방]
겨울만 되면 떠오르는 음식이 있을 것이다. 필자에게는 어린 시절 아랫목에서 먹던 굴전이 그렇다. 칼칼한 총각무와 함께 집어 먹던 그 따뜻한 한 접시가 굴맛을 처음 알게 해준 순간이었다. 이후 음식 공부를 하면서 알게 됐다. 굴은 제철 별미에 그치는 게 아니라 ‘바다의 우유’라 불릴 만…
- 2025-11-23
- 좋아요 개
- 코멘트 개
![겨울철 기력 살릴 ‘바다의 우유’, 굴[정세연의 음식처방]](https://dimg.donga.com/a/296/167/95/2/wps/NEWS/IMAGE/2025/11/23/132823094.4.jpg)
겨울만 되면 떠오르는 음식이 있을 것이다. 필자에게는 어린 시절 아랫목에서 먹던 굴전이 그렇다. 칼칼한 총각무와 함께 집어 먹던 그 따뜻한 한 접시가 굴맛을 처음 알게 해준 순간이었다. 이후 음식 공부를 하면서 알게 됐다. 굴은 제철 별미에 그치는 게 아니라 ‘바다의 우유’라 불릴 만…

“제가 처음 우주의학을 시작할 때만 해도 주변에서 다 미쳤다고 했습니다. 해외에서는 발사체도 없는 나라에서 무슨 우주의학이냐며, 북한보다도 우주 기술에 뒤처진 나라가 아니냐고 했었죠.”이달 27일로 예정된 한국형발사체 ‘누리호’의 4차 발사에 탑재되는 우주 바이오 실험 장비 ‘바이오캐…
전자담배 흡입구의 세균 오염도가 공중화장실 변기보다 최대 3000배 높다는 연구 결과가 공개되며, ‘덜 해롭다’는 인식과 달리 기기 위생 실태가 심각한 수준이라는 지적이 나왔다. 연구진은 전자담배를 사용하는 경우 “최소 3일에 한 번은 세척해야 한다”고 경고했다.19일(현지 시각) 영…

카카오가 다음달 카카오톡 친구탭을 과거 목록형으로 복원한다. 23일 관련 업계에 따르면 카카오는 카카오톡 친구탭에 기존 목록형 사용환경(UI)을 선택할 수 있는 옵션을 추가하는 업데이트를 다음 달 중 실시할 예정이다.앞서 이달 내 복원될 것이란 전망도 있었으나, 카카오는 기능 안정화와…

밤에 뒤척인 날 유난히 배고프고 식욕이 강해지는 것은 과학적 근거가 있는 현상으로, 전문가들은 수면 부족이 체중 증가와 대사 이상을 유발하는 주요 위험 요인이라고 경고한다. 일본 생활건강매체 ‘오토난서’는 21일 내과·당뇨병 전문의 이치하라 유미에 씨의 분석을 인용해 “잠이 부족할수록…